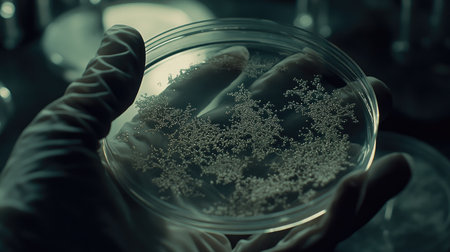
Gloved hand holding a Petri dish filled with complex microorganism patterns, on a sterile lab background, showing detailed microbial growth.の素材

素材 - Gloved hand holding a Petri dish filled with complex microorganism patterns, on a sterile lab background, showing detailed microbial growth.
作品情報
Gloved hand holding a Petri dish filled with complex microorganism patterns, on a sterile lab background, showing detailed microbial growth.
- ID:259917026
- 作品種別:
- 作者名:suphauarrn Manosri
キーワード
- analysis
- analyzing
- biology
- blue
- business
- chart
- close-up
- color image
- colourful
- complex
- complexity
- corporate
- cyber
- digital
- display
- dynamic
- finance
- futuristic
- graph
- hand
- healthcare and medicine
- holding
- holographic
- horizontal
- human hand
- illness
- indicator
- individuality
- information
- innovation
- interactive
- interface
- laboratory
- management
- one person
- pattern
- progress
- research
- science
- scientist
- statistic
- strategy
- technology
- three-dimensional
- touch
- trend
- uk
- virtual
類似作品
A hand, with a ...
handshake of a ...
A hand pointing...
Female doctor b...
cropped view of...
Profile side vi...
Profile side vi...
Male hand in bl...
Doctor and Assi...
Hand in blue pr...
ampoule in a ha...
Woman in blue m...
Folded hands in...
Displaying Empt...
Shaking hands w...
Profile side vi...
Close-up image ...
A white gloved ...
handshake of a ...
Nurse or cosmet...
Person wearing ...
Detail green sc...
Big plastic han...
Doctors in medi...
Sunny frosty wi...
Hands wearing r...
Hands putting o...
men wearing a y...
Female hand wit...
A hand in a lat...
Close up hands ...
Fig as a hand g...
female doctor i...
The doctor puts...
Hand pointing i...
female hand in ...
Monkey hands
Female hands in...
Doctor's hand i...
The gloved hand...
Hand pointing o...
Profile side vi...
hand in a rubb...
The doctor puts...
Symptoms of art...
Thumb down in l...
hand with glove...
female hand in ...
Prevention of i...